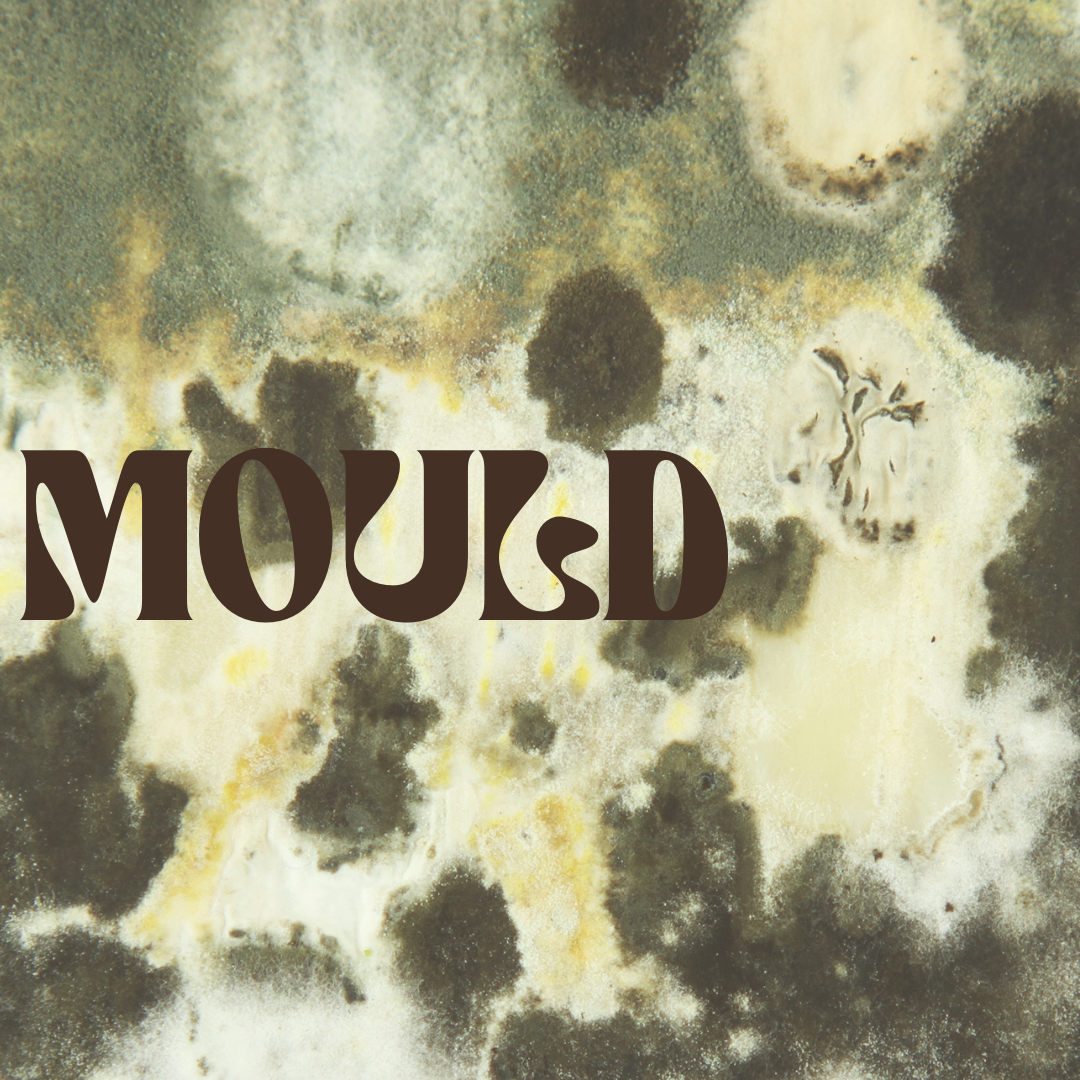
Holistic Healing Journey

Holistic Healing Journey
It's important we continue to look at the natural world and our health as a balancing act. Moving with the seasons and the journey of becoming.
Your internal natural state dear readers is always harmonising and in cahoots with the environment around you.
When you empower your bodies existing and impeccable physiology to detox, the layers of chemicals we are and have been exposed too are able to be released.
Your optimal physiology is geared to thrive, only when we reduce the inflictions, the body can start to regenerate and as such will your experience with life.
Importantly we must remember that it is WITH and not without, nourishment, that we move forward.
Embodying the flow on effect from those many pulses of effort we have along the wellness journey. If we integrate the healing work we are doing we will come to accept our individual process and take control of the narrative around health.
Balance comes with adjusting to how we are moving in life.
As we juggle the entanglement of our experiences and our healing events, we remember and see how they are connected. We all have very real and deep emotional and psycho spiritual healing that underpins the physical in many a ways.
Nature has its functions also, and they must be addressed, as we are not so seperate in many a ways from the nature which surrounds us. It's a reciprocal part of our physical selves. The reconnection and honouring of your Earth Suit will aid you greatly in a cultivated capacity to fully INJoy this journey of Life.
It's all connected baby.
From the food to the faeces.
From the mould to the biotics.
From the cosmos to the fungus.

One example of a natural phenomenon that we live alongside in many tropical places is called Mould. Some may spell mold differently, but mould doesn’t care.
This global aspect of nature is very good at playing its role and alike anything when out of balance, can be rather insidious. When we are over exposed to certain moulds, there can be serious systemic issues that often get overlooked.
Rather, there is a tendency to overlook epigenetics and over diagnose disease states. So mould often goes under the radar for its contribution to mental illness, brain fog, anxiety, chest and breathing issues. In extreme cases of exposure, biotoxic poisoning can occur.
Mycotoxins found within the mould family are not alike typical edible forms of fungus. Certain fungus will enhance the performance of your immune system, mould will actively suppress the immune system. The knock on effect can mean that particular bacterial and viral infections, which were otherwise suppressed, are able to take hold.
We would like to assist you by sharing some information packs on mould and ways to diagnose its presence. There are some tools and recommendations we will continue to share so as to bring more healing awareness to the topic.

The following is an excerpt from a paper looking at the connection between mould and anxiety. We have heard many stories of late regarding mould. None this dramatic necessarily, but its many layers of influence cannot be underestimated. We hope this share serves you well. Blissed and blessed vibrations ya’ll.
“I had found mold in my water damaged office. Shortly thereafter I realized it was also in my home. I had cross-contaminated my house, but it was a year before I knew my house had mold. I had been getting better but not 100%. It was a step I missed because I didn’t want to face the truth of what the consequences would bring - throwing out more stuff. I had already thrown out most of the stuff from my contaminated office BUT not all of the stuff. And I paid dearly for not throwing out ALL the things from my office.
I was in denial and I had toxic mold poisoning. Toxic mold was causing my anxiety and panic attacks and other debilitating symptoms such brain fog, tinnitus, trouble focusing, numbness and tingling in my fingers and toes, crazy fatigue, shortness of breath, nausea, diarrhea/constipation, excessive thirst, vertigo, night sweats and bloody nose.” © 2019 Trudy Scott All Rights Reserved 5










